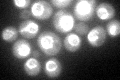
YOR046C
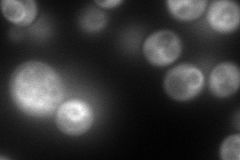
YOR046C
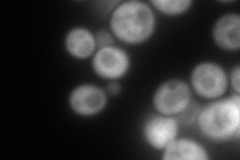
YOR046C
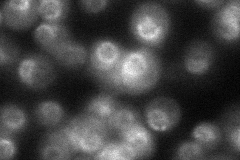
YOR046C
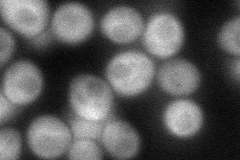
YOR046C
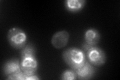
YOR046C
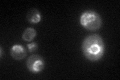
YOR046C

View description
Cytoplasmic ATP-dependent RNA helicase of the DEAD-box family involved in mRNA export from the nucleus; involved in translation termination
Localization:
Intensity:
Fold change:
Significance:
-
C’ GFP library in SD
nuclear periphery94.64 -
N' NOP1pr-GFP in SD
cytosol,ER214.338 -
N' TEF2pr-mCherry in SD
cytosol209.236 -
N' NATIVEpr-GFP in SD
punctate,nuclear periphery39.7732 -
N' TEF2pr-VC and Cyto-VN in SD
cytosol74.0117 -
C’ GFP library in SD+DTT
nuclear periphery94.941No -
C’ GFP library in SD+H2O2

nuclear periphery85.970.9No -
C’ GFP library in Starvation Media
nuclear periphery75.840.8No -
C’ GFP library on the background of Pup2-DaMP

nuclear periphery -
C’ GFP library on the background of CCT mutant

nuclear periphery91.62350.968018No
